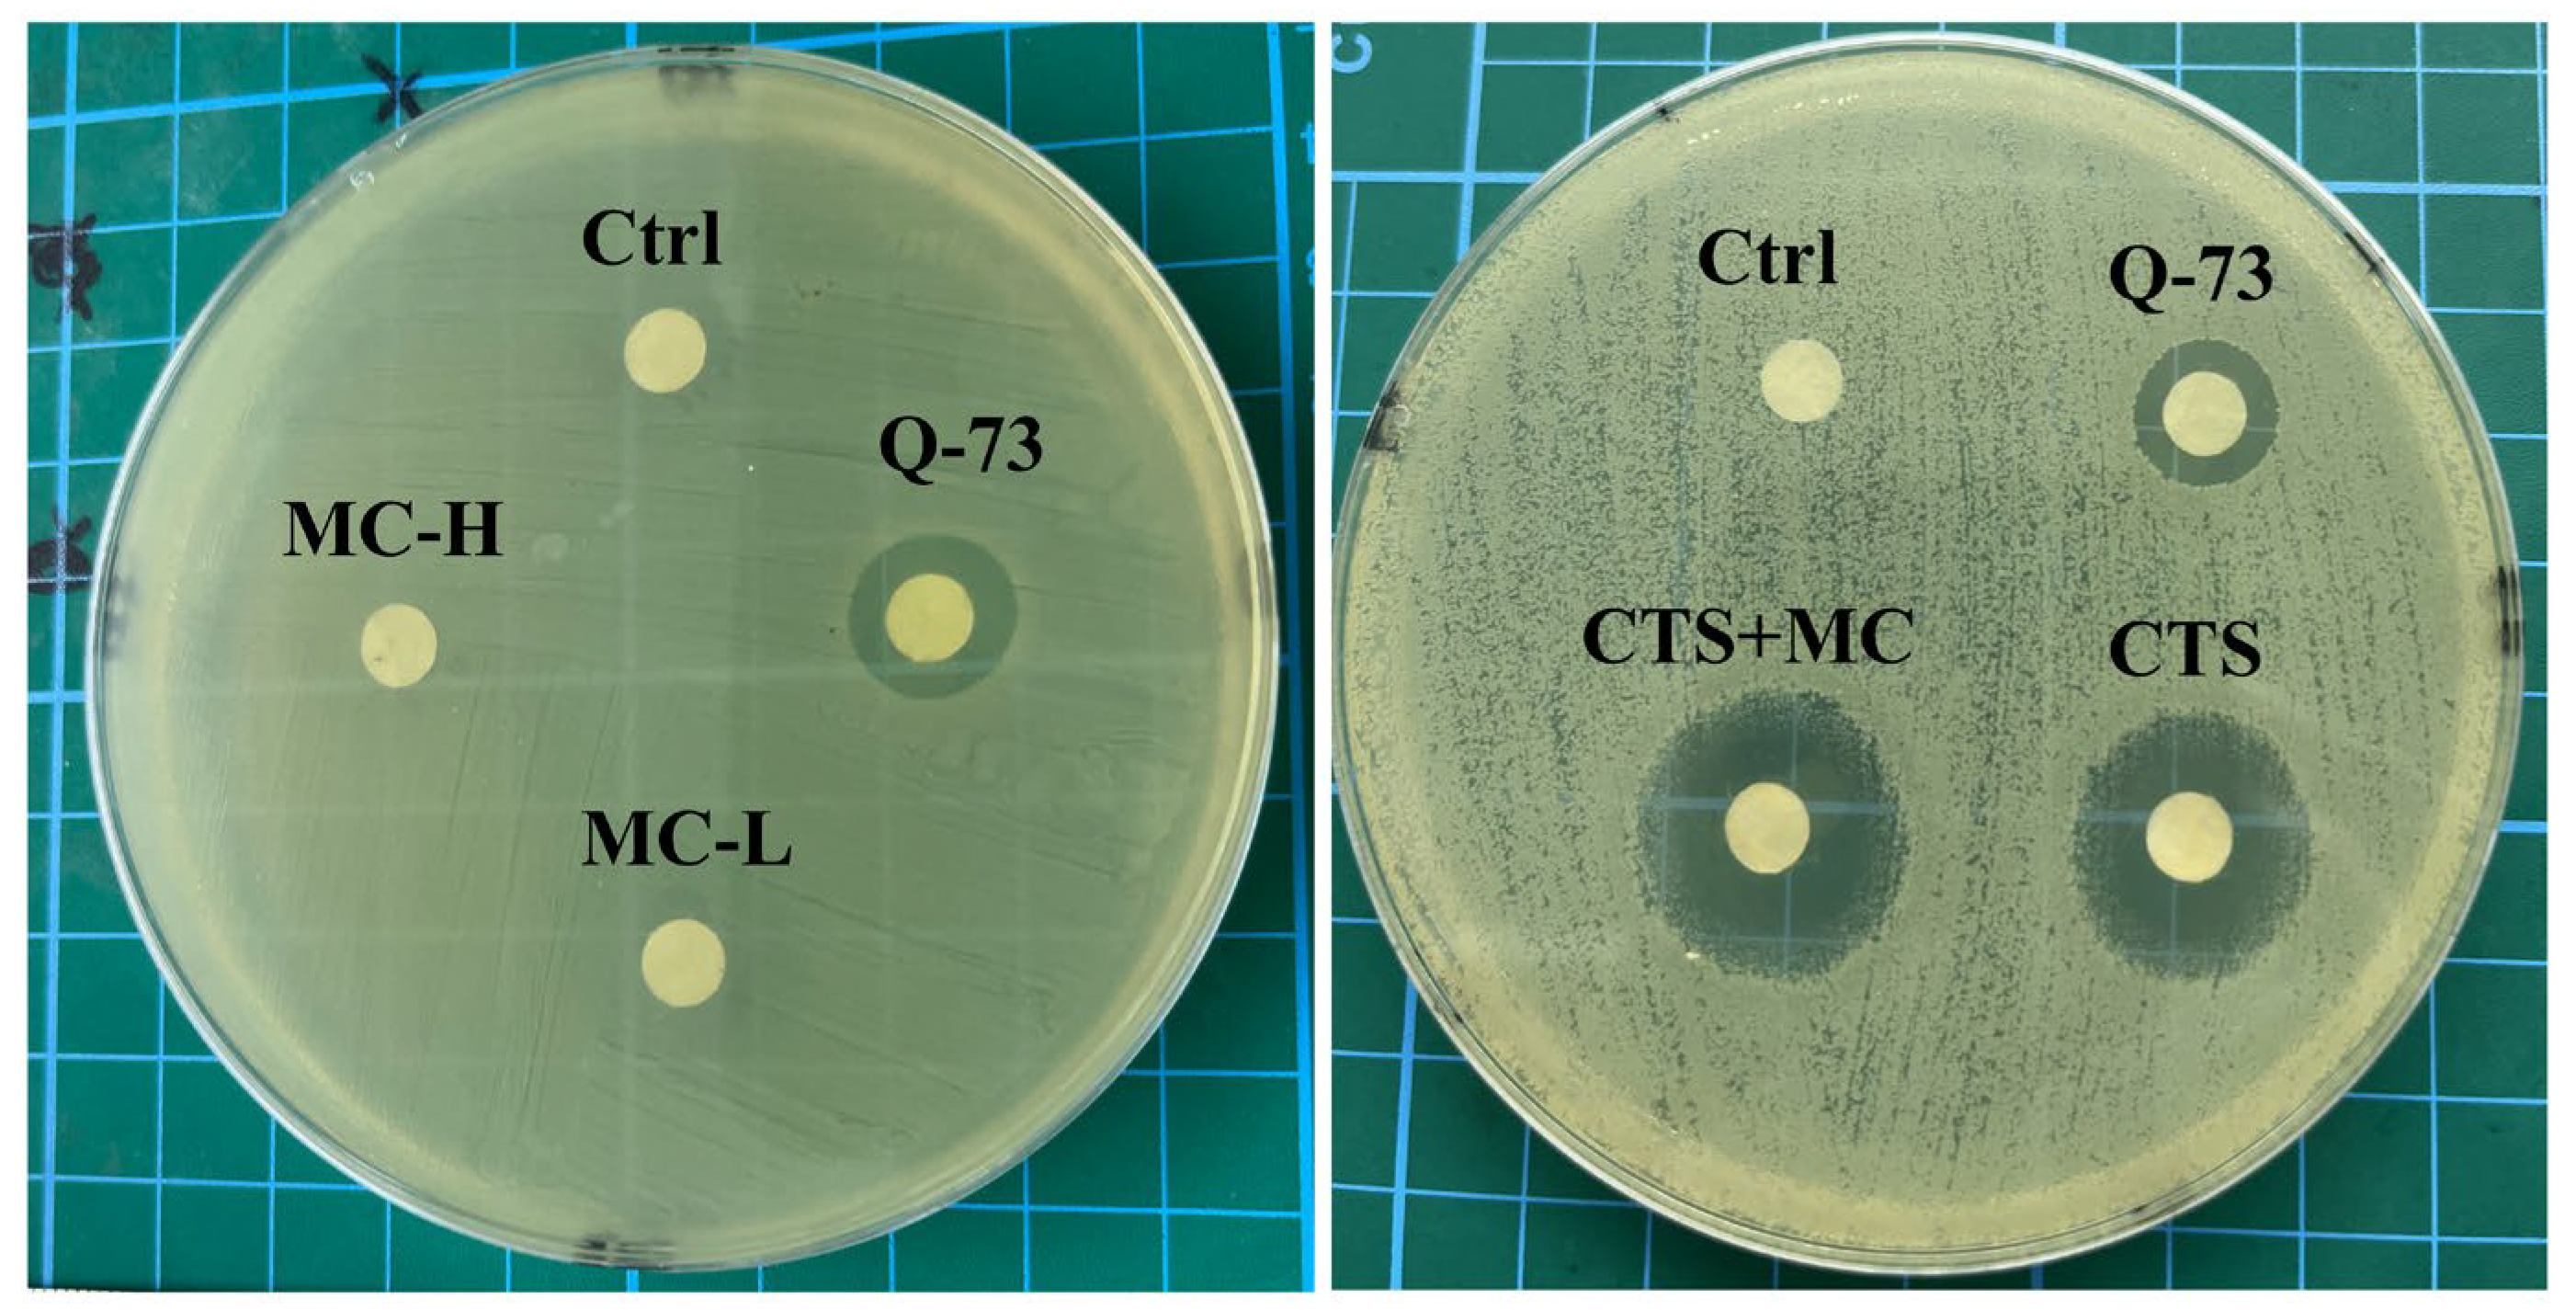
Bioengineering 12 00935 g004 Bioengineering 12 00935 g004

Validation of Madecassoside Synergy Significantly Enhanced Cryptotanshinone’s Therapeutic Efficacy Against Acne Vulgaris
Abstract
1. Introduction
2. Materials and Methods
2.1. Ethics Statement
2.2. Cell Culture
2.3. Cytotoxicity Test
2.4. ELISA Analysis of Inflammatory Cytokines
2.4.1. Cell Stimulation and Supernatant Collection
2.4.2. ELISA Quantification of Inflammatory Factors
2.5. Minimum Inhibition Concentration
2.6. Inhibition Zone
2.7. Zebrafish
2.7.1. Zebrafish Maintenance and Embryo Production
2.7.2. Toxicity and Irritability Assessment in Zebrafish
24 h Acute Toxicity Test
Phenotype Recording
2.7.3. Sodium dodecyl sulfate (SDS)-Induced Zebrafish Embryos Irritancy Model (Self-Rotation Behavior)
2.7.4. High-Dose CTS-Induced Zebrafish Embryos Irritability Model
2.7.5. Pharmacological Attenuation of CuSO4-Induced Neutrophil Migration
2.8. Establishment of Rat Acne Model and Therapeutic Intervention
2.8.1. Formulation Development and Stability Assessment
Solvent Selection
Emulsification process
Formulation Stability Assessment
2.8.2. Oleic Acid-Induced Rat Acne Model and Therapeutic Intervention
2.9. Histopathological Analysis
2.10. Serum Cytokine Quantification
2.11. Data Analysis
3. Results
3.1. The Pharmacological Effects of CTS
3.1.1. Antibacterial Activity of CTS
3.1.2. CuSO4-Induced Neutrophil Migration in 3 dpf Tg(lyz:DsRed) Zebrafish
3.1.3. SDS-Induced Self-Rotation Behavior in 24 hpf embryos of WT AB Zebrafish
3.1.4. CTS Cytotoxicity in Human HaCaT Keratinocytes
3.1.5. Developmental Toxicity in the Zebrafish Model
3.2. MC Influences the Safety Profile of CTS
3.2.1. MC Attenuates CTS Cytotoxicity in HaCaT Cells
3.2.2. MC Modulated CTS-Induced Toxicity in Zebrafish Embryos
3.2.3. MC Reduced CTS-Induced Morphological Abnormalities in Zebrafish at Multiple Developmental Stages
3.3. Antibacterial, Anti-Inflammatory, and Soothing Effects of the MC-CTS Combination
3.3.1. Antibacterial Activity of the CTS-MC Combination
3.3.2. Soothing Effects
SDS-Induced Self-Rotation Behavior in Zebrafish
High-Concentration CTS-Induced Irritancy Model
3.3.3. CuSO4-Induced Neutrophil Migration
3.3.4. Cytokine Modulation in RAW264.7 Cells
3.4. Rat Acne Model and Therapeutic Intervention
3.4.1. Therapeutic Efficacy in Acne Model
3.4.2. H&E
3.4.3. ELISA of Serum
4. Discussion
4.1. Main Research Findings
4.2. Limitations and Future Directions
5. Conclusions
Author Contributions
Funding
Institutional Review Board Statement
Informed Consent Statement
Data Availability Statement
Acknowledgments
Conflicts of Interest
Abbreviations
| ANOVA | Analysis of Variance |
| C. acnes | Cutibacterium acnes (Formerly Propionibacterium acnes) |
| CCK-8 | Cell Counting Kit-8 |
| COX-2 | Cyclooxygenase-2 |
| CTS | Cryptotanshinone |
| DEX | Dexamethasone |
| DG | Dipotassium Glycyrrhizinate |
| DMEM | Dulbecco’s Modified Eagle Medium |
| DMSO | Dimethyl Sulfoxide |
| DPG | Dipropylene Glycol |
| dpf | Days Post-fertilization (Zebrafish Developmental Stage) |
| ECM | Extracellular Matrix |
| ELISA | Enzyme-Linked Immunosorbent Assay |
| EWG | Environmental Working Group |
| FBS | Fetal Bovine Serum |
| GA | Glycyrrhizic acid |
| GTCC | Caprylic/Capric Triglyceride |
| hpf | H Post-fertilization (Zebrafish Developmental Stage) |
| H&E | Hematoxylin–Eosin (Staining) |
| HPF | High-Power Field |
| IC50 | Half-Maximal Inhibitory Concentration |
| IL | Interleukin |
| LC50 | Lethal Concentration 50 |
| LPS | Lipopolysaccharide |
| MC | Madecassoside |
| MIC | Minimum Inhibitory Concentration |
| NADH | Nicotinamide Adenine Dinucleotide (reduced form) |
| NF-κB | Nuclear Factor Kappa-light-chain-enhancer of Activated B cells |
| OD | Optical Density |
| PBS | Phosphate-Buffered Saline |
| PGE2 | Prostaglandin E2 |
| RCM | Reinforced Clostridial Medium |
| ROS | Reactive Oxygen Species |
| SD rats | Sprague–Dawley Rats |
| SDS | Sodium dodecyl sulfate |
| SEM | Standard Error of the Mean |
| S. miltiorrhiza | Salvia miltiorrhiza |
| TLR2 | Toll-like Receptor 2 |
| TNF-α | Tumor Necrosis Factor-alpha |
| WT | Wild-Type |
References
- Kemény, L.; Degovics, D.; Szabó, K. Is There a Place for Biologics in Acne? Am. J. Clin. Dermatol. 2025. online ahead of print. [Google Scholar] [CrossRef]
- Bhatt, J.; Kumar, V.J. Key insights, treatment, and future prospects. In Molecular Diversity; Springer Nature: Berlin/Heidelberg, Germany, 2025. [Google Scholar] [CrossRef]
- Zouboulis, C.C.; Coenye, T.; He, L.; Kabashima, K.; Kobayashi, T.; Niemann, C.; Nomura, T.; Oláh, A.; Picardo, M.; Quist, S.R.; et al. Sebaceous immunobiology—skin homeostasis, pathophysiology, coordination of innate immunity and inflammatory response and disease associations. Front. Immunol. 2022, 13, 1029818. [Google Scholar] [CrossRef]
- Mias, C.; Mengeaud, V.; Bessou-Touya, S.; Duplan, H. Recent advances in understanding inflammatory acne: Deciphering the relationship between Cutibacterium acnes and Th17 inflammatory pathway. J. Eur. Acad. Dermatol. Venereol. 2023, 37, 3–11. [Google Scholar] [CrossRef]
- Zhu, Z.; Zhong, X.; Luo, Z.; Liu, M.; Zhang, H.; Zheng, H.; Li, J. Global, regional and national burdens of acne vulgaris in adolescents and young adults aged 10–24 years from 1990 to 2021: A trend analysis. Br. J. Dermatol. 2025, 192, 228–237. [Google Scholar] [CrossRef] [PubMed]
- Aksu, A.; Kıvanç Altunay, İ.; Kaya, H.E. Assessment of Eating Attitude and Psychiatric Parameters in Patients with Acne Vulgaris. Dermatol. Pract. Concept. 2025, 15, 5053. [Google Scholar] [CrossRef]
- Aleid, A.; Aleid, A.M.; Nukaly, H.Y.; Mustanyir, H.A.A.L.; Almasabi, G.Y.; Alsaeed, A.M.; Nadra, R.W.; Alshammari, B.; Alsaqri, S.H.; Alsaleh, K.; et al. Comparative efficacy of clindamycin phosphate with benzoyl peroxide versus clindamycin phosphate with adapalene in acne vulgaris: A systematic review and meta-analysis. Sci. Rep. 2025, 15, 20478. [Google Scholar] [CrossRef] [PubMed]
- Calvisi, L. Efficacy of a combined chemical peel and topical salicylic acid-based gel combination in the treatment of active acne. J. Cosmet. Dermatol. 2021, 20, 2–6. [Google Scholar] [CrossRef]
- Wang, T.; Yang, C.; Li, Z.; Li, T.; Zhang, R.; Zhao, Y.; Cheng, T.; Zong, Z.; Ma, Y.; Zhang, D.; et al. Flavonoid 4,4′-dimethoxychalcone selectively eliminates senescent cells via activating ferritinophagy. Redox Biol. 2024, 69, 103017. [Google Scholar] [CrossRef]
- Zhu, Y.; Zhao, L.; Yan, W.; Ma, H.; Zhao, W.; Qu, J.; Zheng, W.; Zhang, C.; Du, H.; Yu, M.; et al. Celastrol directly targets LRP1 to inhibit fibroblast-macrophage crosstalk and ameliorates psoriasis progression. Acta Pharm. Sin. B 2025, 15, 876–891. [Google Scholar] [CrossRef]
- Sun, S.; Zhang, X.; Xu, M.; Zhang, F.; Tian, F.; Cui, J.; Xia, Y.; Liang, C.; Zhou, S.; Wei, H.; et al. Berberine downregulates CDC6 and inhibits proliferation via targeting JAK-STAT3 signaling in keratinocytes. Cell Death Dis. 2019, 10, 274. [Google Scholar] [CrossRef]
- Yang, X.; Xiong, B.; Yuan, Z.; Liao, H.; Liu, X.; Wu, Y.; Zhang, S.; Xiang, Q. Polygalaxanthone III, an Active Ingredient in Polygala japonica Houtt., Repaired Malassezia-Stimulated Skin Injury via STAT3 Phosphorylated Activation. Molecules 2022, 27, 7520. [Google Scholar] [CrossRef]
- Prieto, J.M.; Schinella, G.R. Anti-Inflammatory and Antioxidant Chinese Herbal Medicines: Links between Traditional Characters and the Skin Lipoperoxidation “Western” Model. Antioxidants 2022, 11, 611. [Google Scholar] [CrossRef]
- Danielewski, M.; Zielińska, S.; Merwid-Ląd, A.; Szandruk-Bender, M.; Słupski, W.; Włodarczyk, M.; Sozański, T.; Ziółkowski, P.; Szeląg, A.; Nowak, B. Sanguinarine–Chelerythrine from Coptis chinensis Offers Analgesic and Anti-Inflammatory Effects Without Gastrotoxicity. Pharmaceutics 2025, 17, 323. [Google Scholar] [CrossRef] [PubMed]
- Zheng, Y.; Liu, S.; Fan, C.; Zeng, H.; Huang, H.; Tian, C.; Lu, Z.; Cao, H.; Liu, J.; Yu, L. Holistic quality evaluation of Qingwen Baidu Decoction and its anti-inflammatory effects. J. Ethnopharmacol. 2020, 263, 113145. [Google Scholar] [CrossRef] [PubMed]
- Wang, Z.; Liu, L.; Xiang, S.; Jiang, C.; Wu, W.; Ruan, S.; Du, Q.; Chen, T.; Xue, Y.; Chen, H.; et al. Formulation and Characterization of a 3D-Printed Cryptotanshinone-Loaded Niosomal Hydrogel for Topical Therapy of Acne. AAPS Pharmscitech 2020, 21, 159. [Google Scholar] [CrossRef] [PubMed]
- Jiang, Z.; Gao, W.; Huang, L. Tanshinones, critical pharmacological components in Salvia miltiorrhiza. Front. Pharmacol. 2019, 10, 202. [Google Scholar] [CrossRef]
- Sadeghi, Z.; Cerulli, A.; Marzocco, S.; Moridi Farimani, M.; Masullo, M.; Piacente, S. Anti-inflammatory activity of tanshinone-related diterpenes from Perovskia artemisioides roots. J. Nat. Prod. 2023, 86, 812–821. [Google Scholar] [CrossRef]
- Liang, T.; Wu, Y.; Zeng, Q.; Wu, Y.; Zhai, D.; Zheng, Z.; Li, Y.; Xu, Y.; Peng, Y.; Zhu, H.; et al. Development of a self-assembled micelles based on cryptotanshinone and glycyrrhizic acid: An efficient strategy for acne treatment. Int. J. Pharm. 2025, 674, 125411. [Google Scholar] [CrossRef]
- Zeng, Q.; Chen, H.; Wang, Z.; Guo, Y.; Wu, Y.; Hu, Y.; Liang, P.; Zheng, Z.; Liang, T.; Zhai, D.; et al. Carrier-free cryptotanshinone-peptide conjugates self-assembled nanoparticles: An efficient and low-risk strategy for acne vulgaris. Asian J. Pharm. Sci. 2024, 19, 100946. [Google Scholar] [CrossRef]
- Deng, Y.; Feng, R.; Hu, B.; Ren, X.; Zhang, F.; Feng, H.; Wang, X.; Li, Y.; Liu, T.; Cai, L.; et al. Efficacy and safety of Tanshinone capsule in Acne vulgaris: A systematic review and meta-analysis. Front. Pharmacol. 2025, 16, 1520039. [Google Scholar] [CrossRef]
- Li, J.; Wang, M.; Tan, X.; Duanmiao, Y.; Zheng, X.; Wang, Z.; Gao, F.; Miao, Y.; Li, H.; Liu, B.; et al. A dual-component particulate dressing for simultaneous microenvironment modulation and tissue regeneration in infected diabetic wounds. Mater. Today Bio 2025, 33, 102005. [Google Scholar] [CrossRef]
- Witkowska, K.; Paczkowska-Walendowska, M.; Garbiec, E.; Cielecka-Piontek, J. Topical Application of Centella asiatica in Wound Healing: Recent Insights into Mechanisms and Clinical Efficacy. Pharmaceutics 2024, 16, 1252. [Google Scholar] [CrossRef]
- Lim, J.; Lee, H.; Hong, S.; Lee, J.; Kim, Y. Comparison of the Antioxidant Potency of Four Triterpenes of Centella asiatica against Oxidative Stress. Antioxidants 2024, 13, 483. [Google Scholar] [CrossRef]
- Lu, W.; Luo, D.; Chen, D.; Zhang, S.; Chen, X.; Zhou, H.; Liu, Q.; Chen, S.; Liu, W. Systematic Study of Paeonol/Madecassoside Co-Delivery Nanoemulsion Transdermal Delivery System for Enhancing Barrier Repair and Anti-Inflammatory Efficacy. Molecules 2023, 28, 5275. [Google Scholar] [CrossRef]
- Garg, S.; Baveja, S. Combination therapy in the management of atrophic acne scars. J. Cutan. Aesthetic Surg. 2014, 7, 129964. [Google Scholar] [CrossRef]
- Zhang, F.; Wang, T.; Wang, W.; Lv, Y.; Qu, Y.; Liu, D.; Sun, X.; Kong, X.; Wang, C.; Shi, J. ZnO colludes with C. acnes in healing delay and Scar hyperplasia by barrier destruction. J. Nanobiotechnol. 2025, 23, 404. [Google Scholar] [CrossRef] [PubMed]
- Draelos, Z.D.; Kyeremateng, K.; Squittieri, N. Reduction in Facial Sebum Production Following Treatment with Clascoterone Cream 1% in Patients with Acne Vulgaris: 12-Week Interim Analysis. Dermatol. Ther. 2025, 15, 2657–2666. [Google Scholar] [CrossRef] [PubMed]
- Cong, T.-X.; Hao, D.; Wen, X.; Li, X.-H.; He, G.; Jiang, X. From pathogenesis of acne vulgaris to anti-acne agents. Arch. Dermatol. Res. 2019, 311, 337–349. [Google Scholar] [CrossRef] [PubMed]
- Nikolova-Ganeva, K.A.; Mihaylova, N.M.; Kechidzhieva, L.A.; Ivanova, K.I.; Zarkov, A.S.; Parzhanov, D.L.; Ivanov, M.M.; Marchev, A.S. The Therapeutic Potential of Phytochemicals Unlocks New Avenues in the Management of Rheumatoid Arthritis. Int. J. Mol. Sci. 2025, 26, 6813. [Google Scholar] [CrossRef]
- Pacanowska, A.; Regueiro, A.; Clemente-León, M.; Coronado, E.; Forment-Aliaga, A.; Fitta, M. Spin-Crossover Nanoparticles in Electrospun Polymers: A Route to Bistable Materials for Smart Textiles. ACS Appl. Nano Mater. 2025, 8, 15999–16007. [Google Scholar] [CrossRef]
- Herrada Céspedes, A.; Reyes, M.; Morales, J.O. Advanced drug delivery systems for oral squamous cell carcinoma: A comprehensive review of nanotechnology-based and other innovative approaches. Front. Drug Deliv. 2025, 5, 1596964. [Google Scholar] [CrossRef] [PubMed]
- Liu, Y.; Zhao, J.; Mu, X.; Deng, J.; Wu, X.; He, W.; Liu, Y.; Gu, R.; Han, F.; Nie, X. Corrigendum to “Asiaticoside-nitric oxide promoting diabetic wound healing through the miRNA-21-5p/TGF-β1/SMAD7/TIMP3 signaling pathway”. J. Ethnopharmacol. 2025, 337, 119014. [Google Scholar] [CrossRef]
- Krzyżostan, M.; Wawrzyńczak, A.; Nowak, I. Controlled Release of Madecassoside and Asiaticoside of Centella asiatica L. Origin from Sustainable Cold-Processed Topical Formulations. Molecules 2024, 29, 5583. [Google Scholar] [CrossRef]
- Hasegawa, T.; Hall, C.J.; Crosier, P.S.; Abe, G.; Kawakami, K.; Kudo, A.; Kawakami, A. Transient inflammatory response mediated by interleukin-1β is required for proper regeneration in zebrafish fin fold. eLife 2017, 6, e22716. [Google Scholar] [CrossRef]

| Group | Compounds | Concentration Range |
|---|---|---|
| CTS | CTS alone | 0–50 μg/mL + 1% DPG |
| MC | MC alone | 0–2000 μg/mL + 1% DPG |
| CTS + MC | CTS + MC | CTS: 0–2000 μg/mL; MC fixed at 500 μg/mL +1% DPG |
| Control | Culture medium only | 1% DPG |
| Group | Treatment Description | Concentration Range |
|---|---|---|
| Control | DMEM-H medium | / |
| Model | LPS | 1 μg/mL |
| Positive control | LPS + dipotassium glycyrrhizate | 1 μg/mL of LPS; 50 μM of dipotassium glycyrrhizate |
| MC | LPS + MC | 1 μg/mL of LPS; 100 μg/mL of MC |
| CTS | LPS + CTS | 1 μg/mL of LPS; 0.5 μg/mL of CTS |
| CTS + MC | LPS + CTS + MC | 1 μg/mL of LPS; MC (100 μg/mL) + CTS (0.5 μg/mL) |
Disclaimer/Publisher’s Note: The statements, opinions and data contained in all publications are solely those of the individual author(s) and contributor(s) and not of MDPI and/or the editor(s). MDPI and/or the editor(s) disclaim responsibility for any injury to people or property resulting from any ideas, methods, instructions or products referred to in the content. |
© 2025 by the authors. Licensee MDPI, Basel, Switzerland. This article is an open access article distributed under the terms and conditions of the Creative Commons Attribution (CC BY) license (https://creativecommons.org/licenses/by/4.0/).
Share and Cite
Guo, Y.; Yang, X.; Tang, L.; Liang, T.; Xiao, R.; Liu, Q. Validation of Madecassoside Synergy Significantly Enhanced Cryptotanshinone’s Therapeutic Efficacy Against Acne Vulgaris. Bioengineering 2025, 12, 935. https://doi.org/10.3390/bioengineering12090935
Guo Y, Yang X, Tang L, Liang T, Xiao R, Liu Q. Validation of Madecassoside Synergy Significantly Enhanced Cryptotanshinone’s Therapeutic Efficacy Against Acne Vulgaris. Bioengineering. 2025; 12(9):935. https://doi.org/10.3390/bioengineering12090935
Chicago/Turabian StyleGuo, Yaling, Xiaobin Yang, Lifeng Tang, Tao Liang, Rongshen Xiao, and Qiang Liu. 2025. "Validation of Madecassoside Synergy Significantly Enhanced Cryptotanshinone’s Therapeutic Efficacy Against Acne Vulgaris" Bioengineering 12, no. 9: 935. https://doi.org/10.3390/bioengineering12090935
APA StyleGuo, Y., Yang, X., Tang, L., Liang, T., Xiao, R., & Liu, Q. (2025). Validation of Madecassoside Synergy Significantly Enhanced Cryptotanshinone’s Therapeutic Efficacy Against Acne Vulgaris. Bioengineering, 12(9), 935. https://doi.org/10.3390/bioengineering12090935

